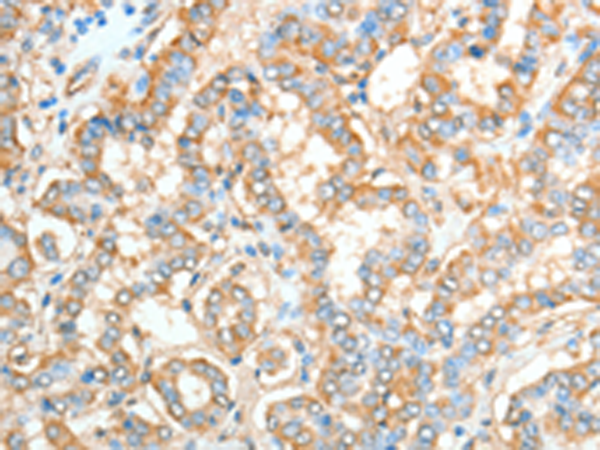
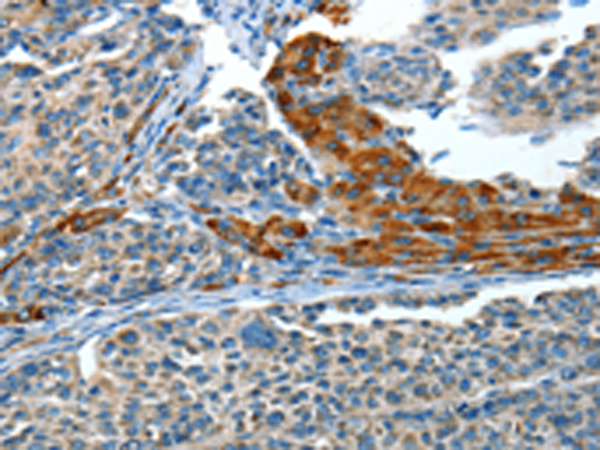

-
分类: 科研抗体货号: P07805别名: HI; p82; CT99; FSC1; PRKA4; AKAP-4; AKAP82; AKAP 82; hAKAP82应用: IHC反应种属: Human
-
分类: 科研抗体货号: P07786别名: ASL; AMPS; ASASE应用: IHC反应种属: Human, Mouse
-
分类: 科研抗体货号: P07770别名: ADA1应用: WB,IHC反应种属: Human, Rat
-
分类: 科研抗体货号: P07803别名: AKAP15; AKAP18应用: WB,IHC反应种属: Human
-
分类: 科研抗体货号: P07785别名: ADDB应用: IHC反应种属: Human
-
分类: 科研抗体货号: P07769别名: ACYPE应用: WB,IHC反应种属: Human, Mouse
-
分类: 科研抗体货号: P07802别名: PHLU; AGXT2L2应用: WB反应种属: Human, Mouse
-
分类: 科研抗体货号: P07784别名: AC4应用: IHC反应种属: Human, Mouse, Rat
-
分类: 科研抗体货号: P07768别名: hTE; PTE1; PTE2; PTE-1; PTE-2; HNAACTE; hACTE-III应用: WB,IHC反应种属: Human, Mouse, Rat
-
分类: 科研抗体货号: P07801别名: ATRAP应用: IHC反应种属: Human

鄂公网安备42018502007531号
鄂公网安备42018502007531号

